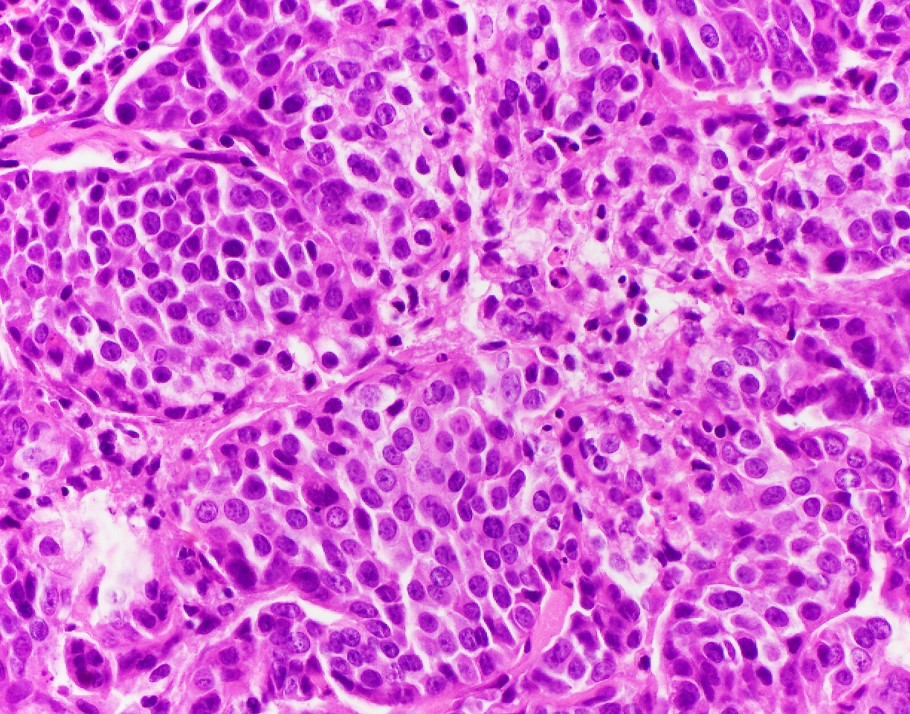
Picture10

Case History
An 81-year-old female with a skull base tumor. Which ancillary test will clinch the diagnosis?
- s100 protein expression
- MART1 expression
- Artginase expression
- An immunostain for INI-1
Answer:
An INI-1 immunostain will show loss in neoplastic cells, confirming the diagnosis of INI-1 (SMARCB1)- deficient sinonasal carcinoma.

Explanation: INI-1 (SMARCB1)-deficient sinonasal carcinoma, currently listed as a subtype of sinonasal undifferentiated carcinoma (SNUC) in the current WHO Classification of Head and Neck Tumors, is a poorly differentiated sinonasal carcinoma defined by loss of nuclear INI-1 expression due to SMARCB1 deletion (1). Histologically, they have a definitive (adeno)carcinoma appearance unlike other INI-1-deficient tumors such as epithelioid sarcoma and atypical teratoid/rhabdoid tumor. INI-1-deficient sinonasal carcinoma shows islands of eosinophilic/oncocytoid and plasmacytoid carcinoma cells with variable glandular differentiation to include focal intracellular/intraluminal mucin production, and may also show a basaloid appearance (2). INI-1 (SMARCB1)-deficient sinonasal carcinoma typically shows expression of CK7. In one report 3 of 10 showed p40 expression, 4 of 12 examples showed CDX2 expression, and 3 of 12 showed CK20 expression (3). Variable/weak expression of neuroendocrine markers has been described. INI-1 (SMARCB1)-deficient sinonasal carcinoma is negative for high-risk HPV and EBV and is negative for S100 protein expression.
The differential diagnosis of INI-1 (SMARCB1)-deficient sinonasal carcinoma includes high-grade non-intestinal sinonasal adenocarcinoma, myoepithelial carcinoma, nonkeratinizing squamous cell carcinoma, mucosal melanoma, etc. All of the entities in the differential diagnosis, except a proportion of myoepithelial carcinomas, retain INI-1 expression. Myoepithelial carcinoma, unlike INI-1 (SMARCB1)-deficient sinonasal carcinoma, should express S100 protein and other myoepithelial markers (3). Recently the morphologic spectrum of INI-1 (SMARCB1)-deficient sinonasal carcinomas has been expanded to included examples with yolk-sac-like areas that have also shown limited glypican-3, SALL4, and HepPar-1 expression, adding germ cell tumor and metastatic hepatocellular carcinoma to the differential diagnosis (3).
INI-1 (SMARCB1)-deficient sinonasal carcinoma is an aggressive malignancy with a mean 15 month survival.
- WHO Classification of Head and Neck Tumours. 4th Lyon. 2017.
- Agaimy A et al. SMARCB1 (INI-1)-deficient sinonasal carcinoma: A Series of 39 Cases Expanding the Morphological and Clinicopathological Spectrum of a Recently Described Entity. Am J Surg Pathol. 2017; 41 (4): 458-471.
- Shah AA et al. SMARCB1 (INI-1)-Deficient Adenocarcinoma of the Sinonasal Tract: A Potentially Under-Recognized form of Sinonasal Adenocarcinoma with Occasional Yolk Sac Tumor-Like Features. Head and Neck Pathology. doi.org/10.1007/s12105-019-01065-7.
Case contributed by: Todd Stevens, M.D., Associate Professor, Anatomic Pathology, UAB Pathology